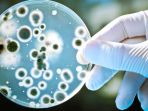

TAG
Amerika Utara
-
Untuk memberikan kenyamanan selama penerbangan, EVA Air selalu memperhatikan setiap detail pelayanannya.
Senin, 3 Juni 2024
-
Bahan bakar jet mahal, dan maskapai penerbangan berupaya semaksimal mungkin untuk pergi dari titik A ke B dalam waktu sesingkat-singkatnya
Kamis, 11 Januari 2024
-
Deretan legenda mengerikan dari Amerika Utara yang menjadi viral, dari skinwalker hingga kurcaci kanibal.
Sabtu, 24 Juni 2023
-
Situs arkeologi Maya terletak sekitar 35 kilometer dari perbatasan Guatemala dan saat ini menjadi Situs Warisan Dunia UNESCO.
Jumat, 28 Oktober 2022
-
Resep es teh manis bisa menjadi minuman yang dibuat di rumah saat siang hari, membuat siang yang panas menjadi adem dan segar.
Rabu, 28 September 2022
-
Kapal pesiar terbesar di dunia, Global Dream II, dijual bahkan sebelum berlayar, alasanya karena biaya produksi yang sangat besar.
Selasa, 6 September 2022
-
Girl group asal Kore Selatan BLACKPINK akan menggelar konser bertajuk 'The Virtual' dalam game PUBG Mobile akhir bulan Juli 2022.
Jumat, 15 Juli 2022
-
Ilmuwan temukan bayi mammoth berbulu di Amerika Utara, Kanada dengan kondisi utuh dan lengkap, termasuk usus, batang tubuh, rambut hingga kulit.
Minggu, 3 Juli 2022
-
Viral di TikTok, sebuah video yang menunjukkan betapa mahalnya harga barang yang dijual di sebuah supermarket yang berlokasi di Alaska.
Jumat, 3 Desember 2021
-
Dilansir TribunTravel dari laman thevintagenews, berikut deretan kota hantu di Amerika Utara yang wajib dijelajahi penggemar misteri.
Senin, 5 Juli 2021
-
The Diabolical Ironclad Beetle layak disebut makhluk paling tangguh di Dunia karena memiliki cangkang yang sangat kuat.
Sabtu, 24 Oktober 2020
-
Ubur-ubur kristal memiliki tubuh sebening kristal yang dapat memancarkan cahaya hijau dan biru swaktu di dalam air.
Rabu, 27 Mei 2020
-
Cathay Pacific Airways menjual tiket kelas bisnis dan first class dengan harga murah setara kelas ekonomi.
Minggu, 6 Januari 2019
-
Salju merupakan partikel uap air yang mendingin di udara dan kemudian jatuh ke bumi. Simak 6 hal menakjubkan dari salju yang jarang sekali diketahui.
Senin, 17 Desember 2018
-
Bersama Brasil, China dan Rusia, saat ini 60 persen infeksi bakteri di Indonesia dinyatakan kebal terhadap (setidaknya) satu jenis antibiotika.
Kamis, 8 November 2018
-
Pernah berkunjung ke pantai dan merasakan air asinnya ? tahukah kamu ternyata ada lima fakta menengejutkan air asin bagi kehidupan manusia di bumi.
Rabu, 17 Oktober 2018
-
Film Crazy Rich Asians sudah mulai tayang di Indonesia. Film yang dibintangi para pemeran keturunan Asia ini berhasil meraih box office di Amerika
Jumat, 14 September 2018
-
Banyak yang mengira, ikan berbahaya dan mengandung racun 'berkumpul' di laut. Namun, di perairan tawar juga ada ikan yang berbahaya.
Sabtu, 4 Agustus 2018
-
Di laut, ada beberapa ikan berbahaya karena mengandung racun. Di perairan tawar juga ada ikan yang berbahaya. Lima ikan ini contohnya.
Jumat, 3 Agustus 2018
-
Tahukah kamu, kebiasaan menyimpan telur di kulkas ternyata bisa berbahaya? Orang Amerika Utara, Australia, Jepang dan Skandinavia melakukan hal ini.
Minggu, 22 Juli 2018
© 2025 TRIBUNnews.com Network,a subsidiary of KG Media.
All Right Reserved
ip-10-0-131-147